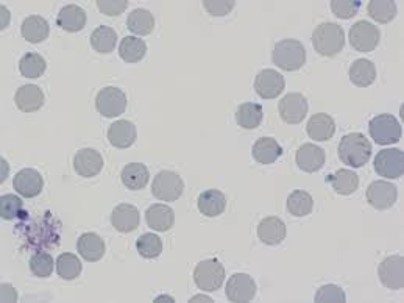

Hemolytic Anemia-Hereditary Enzyme Deficiency (Chapter 10)
1/28
There's no tags or description
Looks like no tags are added yet.
Name | Mastery | Learn | Test | Matching | Spaced | Call with Kai |
|---|
No analytics yet
Send a link to your students to track their progress
29 Terms
Hereditary nonspherocytic hemolytic anemia (HNSHA)
Group of inherited disorders - RBCs are destroyed but do NOT become spherical
What is the most common cause of Hereditary nonspherocytic hemolytic anemia?
Glucose-6-phosphate dehydrogenase (G6PD) enzyme abnormalities
G6PD
An important enzyme that protects RBCs from oxidative damage
Class 1 variant G6PD enzyme deficiency
<10% normal enzymatic activity with chronic hemolytic anemia
Class 2 variant G6PD enzyme deficiency
Severe enzyme deficiency with intermittent episodes of acute hemolysis
What groups of people are associated with G6PD enzyme variants?
African
Mediterranean
Middle Eastern
Asian
G6PD deficiency is more common in which sex?
Male
A blood smear stained with Romanowsky stain shows bite cells, what could this possibly be an indicator of?
G6PD enzyme deficiency
A blood smear contained Heinz bodies, what could this be an indicator of?
G6PD enzyme deficiency
What is on this slide?
Heinz bodies

What is on this slide?
Bite cells
Patients with G6PD abnormalities are usually asymptomatic until exposed to:
Conditions of lowered oxygen tension
Certain chemicals or substance (including fava beans)
Some medications
After a hemolytic episode, the RBC count will ________ 2-3 days later.
Decrease
A patient who had experienced a hemolytic episode would have what kinds of anemia?
Normochromic
Normocytic
A patient who had experienced a hemolytic episode would likely have ________ reticulocyte counts
Increased
What is the proper treatment for hemolytic anemia?
RBC transfusion
Pyruvate kinase (PK)
Essential enzyme of the Embden-Meyerhof pathway
What is the second most common enzyme abnormality associated with Hereditary nonspherocytic hemolytic anemia?
Pyruvate Kinase
Pyruvate kinase deficiency
A diminished capacity to generate ATP, resulting in fragile RBCs & hemolytic anemia
Normally, the peripheral blood contains __ MetHgb
<1%
A deficiency of MetHgb reductase allows _____ to accumulate
MetHgb
MetHgb
When iron in hemoglobin is oxidized from the ferrous (Fe2+) to the ferric (Fe3+) state
It cannot bind and transport O2 effectively
What can cause methemoglobininemia?
A rare mutation found on the CYB5R3 gene as an autosomal recessive trait
Type I methemoglobininemia
Functional anemia (mild symptoms)
Affinity for oxygen is significantly decreased in RBCs (blue skin)
Type II methemoglobininemia
Complications such as neurological impairment, mental impairment & growth malformations occur (Enz deficiency throughout the whole body)
What is the major clinical feature of a methemoglobin mutation?
Cyanosis (blue skin)
Although benign, patients with methemoglobin mutations can be treated with:
Methylene blue by IV
How does methylene blue help in patients with Methemoglobin mutations?
Converts MetHb (Fe3+) back to normal hemoglobin (Fe2+) by activating an enzyme system called NADH-methemoglobin reductase
Due to methemoglobin being unable to carry oxygen, patients with the methemoglobin mutation may have:
Anemia-like symptoms or develop extra RBCs to compensate